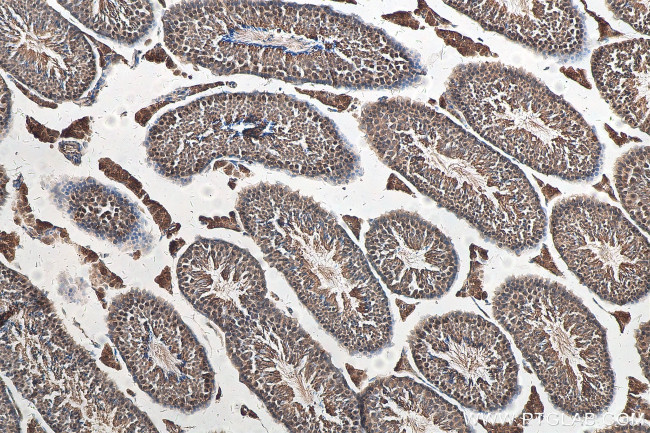
ATR Antibody in Immunohistochemistry (Paraffin) (IHC (P))

Search
Proteintech
ATR Polyclonal Antibody
{{$productOrderCtrl.translations['antibody.pdp.commerceCard.promotion.promotions']}}
{{$productOrderCtrl.translations['antibody.pdp.commerceCard.promotion.viewpromo']}}
{{$productOrderCtrl.translations['antibody.pdp.commerceCard.promotion.promocode']}}: {{promo.promoCode}} {{promo.promoTitle}} {{promo.promoDescription}}. {{$productOrderCtrl.translations['antibody.pdp.commerceCard.promotion.learnmore']}}
产品信息
19787-1-AP
种属反应
已发表种属
宿主/亚型
分类
类型
抗原
偶联物
形式
浓度
规格
纯化类型
保存液
内含物
保存条件
运输条件
产品详细信息
The antibody can recognize all the isoform of ATR.
靶标信息
The protein encoded by this gene is a serine/threonine kinase and DNA damage sensor, activating cell cycle checkpoint signaling upon DNA stress. The encoded protein can phosphorylate and activate several proteins involved in the inhibition of DNA replication and mitosis, and can promote DNA repair, recombination, and apoptosis. This protein is also important for fragile site stability and centrosome duplication. Defects in this gene are a cause of Seckel syndrome 1.
仅用于科研。不用于诊断过程。未经明确授权不得转售。
生物信息学
蛋白别名: 2310008J16Rik; 2810405N18Rik; Ataxia telangiectasia and Rad3-related protein; atr; ATR serine/threonine kinase; EC 2.7.11.1; FRAP-related protein 1; FRAP-related protein-1; kinase ATR; MEC1, mitosis entry checkpoint 1, homolog; protein kinase ATR; Serine/threonine-protein kinase ATR; TEM8
基因别名: ATR; FCTCS; FRP1; MEC1; SCKL; SCKL1
UniProt ID: (Human) Q13535
Entrez Gene ID: (Human) 545, (Mouse) 245000